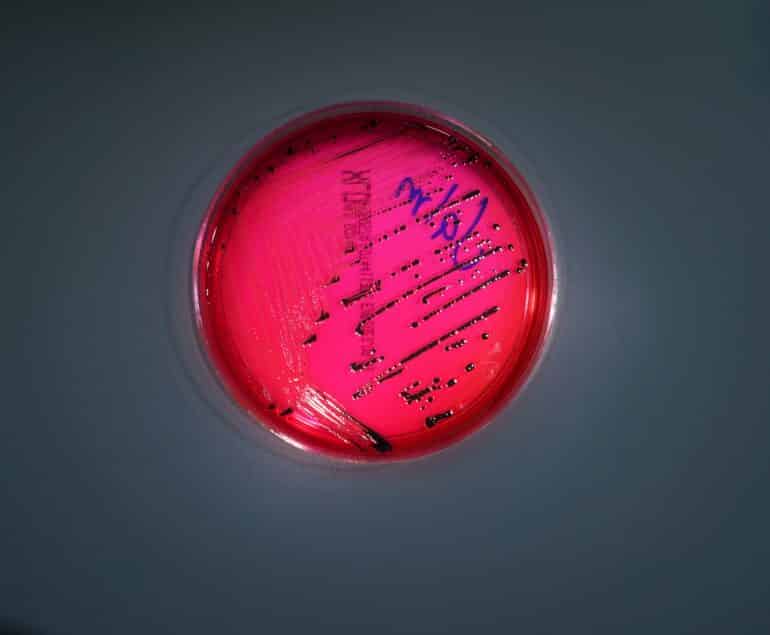

Novum Analytik GmbH
Im Riedgrund 8, 74078 Heilbronn
- Mikrobiologische Analyse von Lebensmitteln
- Getrocknete Lebensmittel
- Michlprodukte
- Lebensmittelhersteller
- Verarbeitung von Lebensmitteln
- Importeure von Gewürzen und Kräutern
- Molkereien
- DIN EN ISO/IEC 17025:2018
Die Novum Analytik GmbH hat sich auf den Nachweis von Mikroorganismen in Lebensmitteln mittels mikrobiologischer und molekulargenetischer Verfahren spezialisiert.
Zum Analysespektrum in dem nach DIN EN ISO/IEC 17025:2018 akkreditiertem Bereich zählt u.a. Bestimmung von Bakterien, Hefen und Schimmelpilzen in Lebensmitteln mittels kultureller mikrobiologischer Untersuchung, Nachweis von Shiga-Toxin bildenden Escherichia coli (STEC) und Salmonellen in Lebensmitteln mittels PCR, Bestimmung des Oberflächenkeimgehaltes auf Einrichtungs- und Bedarfsgegenständen entlang der Lebensmittelkette sowie Probennahme und mikrobiologische Untersuchungen gemäß Trinkwasserverordnung.
Erfahrung, Kompetenz und unsere Leidenschaft für Spitzenleistungen garantieren Ihnen ein Höchstmaß an Sicherheit. Bereits seit 1991 vertrauen unsere Kunden auf die maßgeschneiderten Angebote rund um die mikrobiologischen Lebensmitteluntersuchungen.